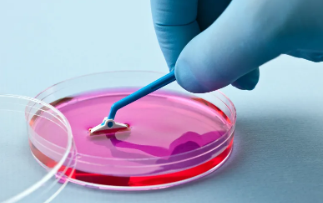
image.png

在哪里打干細(xì)胞效果比較好?有哪些高性價比機(jī)構(gòu)?
2024-11-01 14:03:05 來源: 小編 咨詢醫(yī)生
本文將詳細(xì)介紹干細(xì)胞治療的相關(guān)知識,以及全球范圍內(nèi)一些知名的高性價比干細(xì)胞治療機(jī)構(gòu)。
干細(xì)胞治療作為一種先進(jìn)的生物技術(shù),近年來在國內(nèi)外得到了廣泛關(guān)注。它通過注射或移植具有自我復(fù)制和分化能力的干細(xì)胞,來修復(fù)受損的器官或組織,達(dá)到治療疾病的目的。那么,在哪里打干細(xì)胞效果比較好?又有哪些高性價比的機(jī)構(gòu)呢?以下是一些相關(guān)信息。
一、在哪里打干細(xì)胞效果比較好?
1.國內(nèi):我國在干細(xì)胞治療領(lǐng)域的研究和應(yīng)用處于世界領(lǐng)先水平,部分技術(shù)和成果已達(dá)到國際先進(jìn)水平。國內(nèi)許多知名的三甲醫(yī)院都設(shè)有干細(xì)胞治療中心,如北京協(xié)和醫(yī)院、上海交通大學(xué)醫(yī)學(xué)院附屬仁濟(jì)醫(yī)院等。
2.國外:美國、英國、日本等發(fā)達(dá)國家在干細(xì)胞治療領(lǐng)域也有著豐富的經(jīng)驗(yàn)和研究成果。其中,美國是世界上干細(xì)胞治療技術(shù)最成熟的國家之一,擁有許多知名的干細(xì)胞治療機(jī)構(gòu)。
二、有哪些高性價比機(jī)構(gòu)?
1.北京協(xié)和醫(yī)院:作為國內(nèi)干細(xì)胞治療的領(lǐng)軍機(jī)構(gòu),北京協(xié)和醫(yī)院在干細(xì)胞治療領(lǐng)域有著豐富的經(jīng)驗(yàn)和研究成果。醫(yī)院擁有一流的專家團(tuán)隊(duì)和先進(jìn)的實(shí)驗(yàn)室設(shè)備,為患者提供個性化的治療方案。
2.上海交通大學(xué)醫(yī)學(xué)院附屬仁濟(jì)醫(yī)院:該醫(yī)院在國內(nèi)干細(xì)胞治療領(lǐng)域具有較高的聲譽(yù),擁有一支經(jīng)驗(yàn)豐富的專家團(tuán)隊(duì)。在干細(xì)胞治療神經(jīng)系統(tǒng)疾病、心血管疾病等方面取得了顯著成果。
3.美國匹茲堡大學(xué)醫(yī)學(xué)中心(UPMC):UPMC是全球知名的干細(xì)胞治療機(jī)構(gòu),擁有世界一流的專家團(tuán)隊(duì)和實(shí)驗(yàn)室設(shè)備。在干細(xì)胞治療神經(jīng)系統(tǒng)疾病、心血管疾病等領(lǐng)域具有豐富的經(jīng)驗(yàn)。
4.英國倫敦大學(xué)學(xué)院醫(yī)院(UCLH):UCLH是英國領(lǐng)先的干細(xì)胞治療中心,擁有一支專業(yè)的醫(yī)療團(tuán)隊(duì)。在干細(xì)胞治療血液病、神經(jīng)系統(tǒng)疾病等方面取得了顯著成果。
5.日本東京大學(xué)醫(yī)學(xué)部附屬病院:東京大學(xué)醫(yī)學(xué)部附屬病院在干細(xì)胞治療領(lǐng)域具有較高的地位,擁有一流的專家團(tuán)隊(duì)和先進(jìn)的實(shí)驗(yàn)室設(shè)備。在干細(xì)胞治療肝臟疾病、神經(jīng)系統(tǒng)疾病等方面取得了顯著成果。
總之,選擇干細(xì)胞治療機(jī)構(gòu)和地點(diǎn)時,患者應(yīng)綜合考慮專家團(tuán)隊(duì)、技術(shù)實(shí)力、治療費(fèi)用等因素。在國內(nèi)外都有許多高性價比的干細(xì)胞治療機(jī)構(gòu),患者可以根據(jù)自身情況選擇合適的機(jī)構(gòu)和地點(diǎn)。同時,建議患者在治療前充分了解相關(guān)知識和信息,與專業(yè)醫(yī)生進(jìn)行溝通,以確保治療效果和安全。
- 2024-08-16造血干細(xì)胞來源,造血干細(xì)胞的三個來源
- 2024-10-19捐造血干細(xì)胞對身體有害嗎,捐造血干細(xì)胞好處和壞處
- 2024-10-23禪城醫(yī)院干細(xì)胞中心治療技術(shù)領(lǐng)先嗎?成功率多高?
- 2024-10-12阜陽造血干細(xì)胞有何功效?適用于哪些疾病治療?
- 2024-11-06視網(wǎng)膜干細(xì)胞移植手術(shù)成功率如何?術(shù)后注意事項(xiàng)有哪些?
- 2024-11-05打完干細(xì)胞后需要注意哪些事項(xiàng)?
- 2024-09-10深圳做干細(xì)胞免疫機(jī)構(gòu)排名榜單
- 2024-09-11干細(xì)胞提取過程,干細(xì)胞提取方法和設(shè)備
- 2024-09-11抗衰老干細(xì)胞怎樣提取,從哪里提取
- 2024-09-13中國干細(xì)胞十大公司排名,干細(xì)胞什么牌子比較好
- 2024-08-28甲狀腺結(jié)節(jié)用干細(xì)胞療法有用嗎多少錢
- 2024-09-20造血干細(xì)胞移植要多少錢,附上費(fèi)用明細(xì)表
- 2024-08-05干細(xì)胞治療卵巢早衰,卵巢干細(xì)胞一針多少錢
- 2024-10-10天津干細(xì)胞價格貴嗎?如何選擇性價比高的治療?
- 2024-09-11干細(xì)胞存儲機(jī)構(gòu)排名,干細(xì)胞十大公司排名及價格
- 2024-09-11抗衰老干細(xì)胞怎樣提取,從哪里提取
- 2024-08-07干細(xì)胞生發(fā)技術(shù),干細(xì)胞生發(fā)技術(shù)成熟嗎
- 2024-09-06干細(xì)胞允許研究到什么程度,你知道嗎
